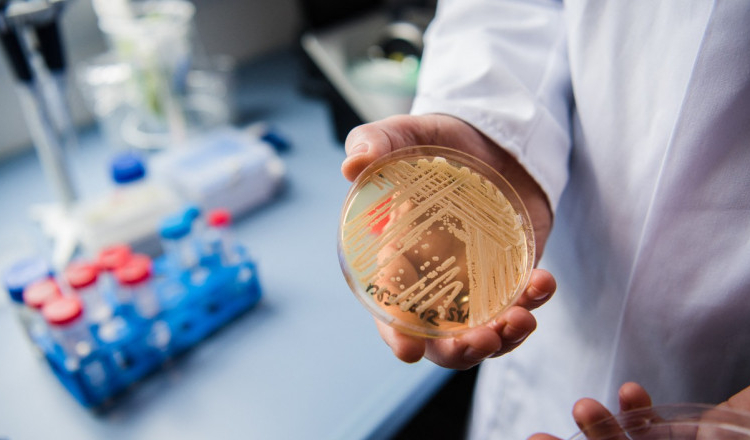
O ciupercă mortală rezistentă la medicamente se răspândește într-un ritm îngrijorător

O ciupercă rezistentă la medicamente și potențial mortală, care poate afecta persoanele cu sistemul imunitar slăbit, se răspândește rapid, avertizează cercetătorii americani de la Centrul de Control și Prevenire a Bolilor, scrie Sky News.
Potrivit acestora, este vorba despre o ciupercă, Candida auris, care a fost identificată în Asia în 2009, dar a fost raportată pentru prima dată în SUA în 2016.
Numărul de persoane diagnosticate, precum și a celor care sunt purtătoare de Candida auris – fapt constatat prin screening – a crescut într-un ritm alarmant începând din 2016.
RelatedPosts
Oamenii de știință spun că ciuperca a fost depistată pentru prima dată în întreaga lume cu zece ani în urmă.
Meghan Lyman, director medical al filialei CDC pentru boli micotice, a declarat că această creltere din ultimii ani este îngrijorătoare. „Am văzut creșteri nu doar în zonele de transmitere în curs, ci și în zone noi”, a spus ea.
Meghan Lyman a adăugat că este îngrijorător și faptul că tot mai multe analize arată o creștere a numărului de ciuperci rezistente la tratamentele obișnuite.
Waleed Javaid, epidemiolog și director la centrul pentru prevenirea și controlul infecțiilor din New York, a declarat că ciuperca este „îngrijorătoare”.
„Oamenii care s-au uitat la „The Last Of Us” să nu creadă acum că vom muri cu toții. Aceasta este o infecție care apare la persoane foarte bolnave, de obicei bolnavi cu o mulțime de alte probleme”, a adăugat el.
Ciuperca nu reprezintă o amenințare pentru oamenii sănătoși. Dar aproximativ o treime dintre persoanele care se îmbolnăvesc cu Candida auris mor, avertizează cercetătorii.
Ciuperca a fost descoperită în peste jumătate dintre statele americane. Numărul de infecții în SUA a crescut cu 95% între 2020 și 2021.
Noul studiu vine în contextul în care Mississippi se confruntă cu un focar tot mai mare al ciupercii. Din noiembrie, 12 persoane din acest stat au fost infectate, iar patru oameni au murit, decesele fiind „potențial asociate” acestei ciuperci, potrivit departamentului de sănătate al statului.
 Acasa
Acasa

Declinare de responsabilitate pentru comentarii
Declinare de responsabilitate pentru comentarii

